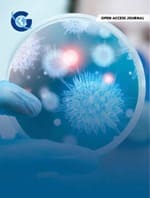
Curcumin and Colistin are Synergistic in  Inhibiting the Growth and Biofilm Formation of Pseudomonas aeruginosa Isolated from Environmental Sample

research article

A Retrospective Observational Study on The Effect of Steroid Use in Covid-19 Patients
Rakesh Sanker, Srinivasa Rao Polumuru, Pavan Shrivastava, Lexy Vijayan, Mohamed Soliman, Salini Sasidharan, Keerthana Kalliat
Infectious Diseases Diagnosis & Treatmentcase report

Native Joint Septic Arthritis Due to Rothia mucilaginosa: A Case Report and Literature Review
Alessa Fischer, Isabel Akers, Daniel Baunach, Roberto Buonomano
Infectious Diseases Diagnosis & Treatmentresearch article

Correlation of Clinical Findings with Innate Immunity Against SARS-CoV-2 and Nucleic Acid Expression of SARS-CoV-2 Among Patients in Mongolia
Ankhbayar Sandagdorj, Naranzul Tsedenbal, Bayasgalan Namuutsetseg, Sarangua Ganbold, Khishigmunkh Chimedregzen, Uuganchimeg Munkhbayar, Gantsooj Baatar, Khurelbaatar Chuluundorj, Darmaa Badarch, Purevbat Bazarjav, Enkhsaikhan Lkhagvasuren, Nyamdavaa
Infectious Diseases Diagnosis & TreatmentResearch Article

Evaluation of Diagnostic Accuracy of Rapid SARS-CoV-2 Antigen Detection Kits Used in Public Testing Centers in Mongolia
Purevbat Bazarjav,, Ankhbayar Sandagdorj, Bayarzaya Artbazar, Batchimeg Khishigjargal, Narantsetseg Baatarsuren, Shijir Lkhagvasuren, Naranzul Tsedenbal, Darmaa Badarch, Oyunsuren Enebish, Erdembileg Tsevegmid, Enkhbold Sereejav, Bumdelger Batmunkh,
Infectious Diseases Diagnosis & TreatmentResearch Article
Curcumin and Colistin are Synergistic in Inhibiting the Growth and Biofilm Formation of Pseudomonas aeruginosa Isolated from Environmental Sample
Barkha Modi, Sabarnee Bahadur, Priyanka Bhowmik, Soumyananda Chakraborti, Anjaneyulu Dirisala, Ali Hossain Khan, Abhrajyoti Ghosh, Sangita Mondal, Amit Ranjan Maity, Arnab Basu
Infectious Diseases Diagnosis & TreatmentCase Report

Long Covid Patients Successfully Treated by Means of Heparin-Mediated Extracorporeal LDL Precipitation (H.E.L.P.) Apheresis
Beate Roxane Jaeger, Hayley Emma Arron,, Renata Madre Booyens, Christiane Kappert, Josef van Helden, Maud Weimer, Oliver Weingärtner, Rainer Seibel, Franz Reichl, Asad Khan,, Dietrich Seidel
Infectious Diseases Diagnosis & TreatmentResearch Article

HIV and Covid 19 Coinfection, A Local Perspective: A Retrospective Study from Qatar
Hussam Alsoub, Abdullatif AlKhal, Muna Al Maslamani, Joanne Daghfal Nader
Infectious Diseases Diagnosis & TreatmentResearch Article
Brief Report

Leptospirosis in the Tel Aviv District, Israel, 2016-2022
Rivka Sheffer, Michal Savion, Naama Nuss, Ziva Amitai, Matanelle Salama
Infectious Diseases Diagnosis & TreatmentCase Series

An Unusual Cluster of Roseomonas mucosa Cases in a Hospital System: Related or Not?
Evann E. Hilt, Jennifer L. Dale, Bradley Craft, Patricia Ferrieri
Infectious Diseases Diagnosis & TreatmentResearch Article

Half Reaction Volume Optimization of Viral Load Real Time PCR: Lessons, Challenges, and Experience in A Resource Limited Setting
Pooja Pandey, Aparna Pandey, Juhi Taneja, Sanchi Kashyap, Rajiv Mohan Gupta, Priti Agarwal, Asim Das, Anil K Pandey
Infectious Diseases Diagnosis & TreatmentReview Article

Deciphering the Structural and Functional Properties of ABC-F ATPases
Chiranjeet Saha†, Sujata Saha†, Asmita Chakraborty, Anjaneyulu Dirisala, Amit Ranjan Maity, Priyanka Bhowmik, Kunal Sikder, Soumyananda Chakraborti, Arnab Basu
Infectious Diseases Diagnosis & Treatment


